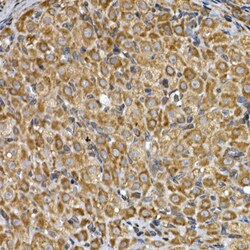

Promotional price valid on web orders only. Your contract pricing may differ. Interested in signing up for a dedicated account number?
Learn More
Learn More
Invitrogen™ INSIG2 Polyclonal Antibody


Rabbit Polyclonal Antibody
Supplier: Invitrogen™ PA5109863
Description
Immunogen sequence: QIQRNVTLFP PDVIASIFSS AWWVPPCCGT ASAVIGLLYP CIDRHLGEPH KFKREWSSVM RCVAVFVGIN HASAKVDFDN NIQLSLTLAA LSIGLWWTFD R.
INSIG2 is highly similar to the protein product encoded by gene INSIG1. Both INSIG1 protein and this protein are endoplasmic reticulum proteins that block the processing of sterol regulatory element binding proteins (SREBPs) by binding to SREBP cleavage-activating protein (SCAP), and thus prevent SCAP from escorting SREBPs to the Golgi.The protein encoded by this gene is highly similar to the protein product encoded by gene INSIG1. Both INSIG1 protein and this protein are endoplasmic reticulum proteins that block the processing of sterol regulatory element binding proteins (SREBPs) by binding to SREBP cleavage-activating protein (SCAP), and thus prevent SCAP from escorting SREBPs to the Golgi.
Specifications
| INSIG2 | |
| Polyclonal | |
| Unconjugated | |
| INSIG2 | |
| 2900053I11Rik; C730043J18Rik; Insig2; INSIG-2; INSIG2 membrane protein; INSIG-2 membrane protein; insulin induced factor 2; insulin induced gene 2; insulin induced protein 2; insulin-induced 2 protein; insulin-induced gene 2 protein; insulin-induced membrane protein 2; MGC26273 | |
| Rabbit | |
| Affinity Chromatography | |
| RUO | |
| 288985, 51141, 72999 | |
| -20°C, Avoid Freeze/Thaw Cycles | |
| Liquid |
| ELISA, Immunohistochemistry (Paraffin), Western Blot | |
| 0.95 mg/mL | |
| PBS with 50% glycerol and 0.05% ProClin 300; pH 7.3 | |
| Q80UA9, Q91WG1, Q9Y5U4 | |
| INSIG2 | |
| A synthetic peptide corresponding to a sequence within amino acids 50-150 of human INSIG2 (NP_057217.2). | |
| 100 μL | |
| Primary | |
| Human, Mouse, Rat | |
| Antibody | |
| IgG |
Safety and Handling
WARNING: Cancer - www.P65Warnings.ca.gov
Product Content Correction
Your input is important to us. Please complete this form to provide feedback related to the content on this product.
Product Title
Spot an opportunity for improvement?Share a Content Correction